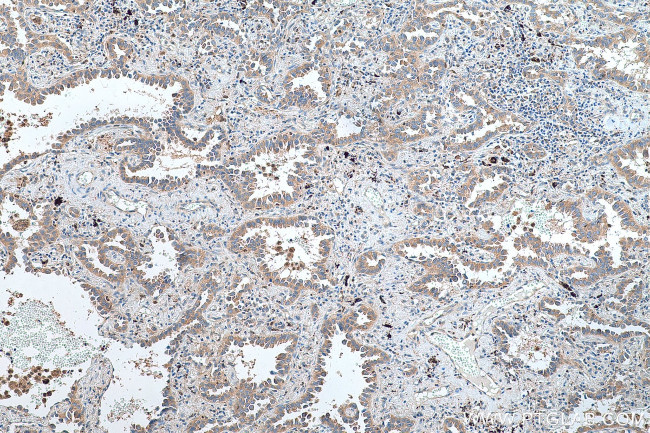
SDCCAG1 Antibody in Immunohistochemistry (Paraffin) (IHC (P))

Search
Proteintech
SDCCAG1 Polyclonal Antibody
{{$productOrderCtrl.translations['antibody.pdp.commerceCard.promotion.promotions']}}
{{$productOrderCtrl.translations['antibody.pdp.commerceCard.promotion.viewpromo']}}
{{$productOrderCtrl.translations['antibody.pdp.commerceCard.promotion.promocode']}}: {{promo.promoCode}} {{promo.promoTitle}} {{promo.promoDescription}}. {{$productOrderCtrl.translations['antibody.pdp.commerceCard.promotion.learnmore']}}
产品信息
11840-1-AP
种属反应
宿主/亚型
分类
类型
抗原
偶联物
形式
浓度
规格
纯化类型
保存液
内含物
保存条件
运输条件
产品详细信息
Immunogen sequence: EDITLQSGR DELNEELIQE ESSEDEGEYE EVRKDQDSVG EMKDEGEETL NYPDTTIDLS HLQPQRSIQK LASKEESSNS SDSKSQSRRH LSAKERREMK KKKLPSDSGD LEALEGKDKE KESTVHIETH QNTSKNVAAV QPMKRGQKSK MKKMKEKYKD QDEEDRELIM KLLGSAGSNK EEKGKKGKKG KTKDEPVKKQ PQKPRGGQRV SDNIKKETPF LEVITHELQD FAVDDPHDDK EEQDLDQQGN EENLFDSLTG QPHPEDVLLF AIPICAPYTT MTNYKYKVKL TPGVQKKGKA AKTALNSFMH SKEATAREKD LFRSVKDTDL SRNIPGKVKV SAPNLLNVKR K (48-397 aa encoded by BC020794)
靶标信息
NEMF (SDCG1) plays a role in nuclear export and is expressed in brain, heart, liver, lung, spleen, and skeletal muscle. Also expressed at lower levels in stomach and testis.
仅用于科研。不用于诊断过程。未经明确授权不得转售。
生物信息学
蛋白别名: Antigen NY-CO-1; caliban homolog; New-York Colon 1; Nuclear export mediator factor; nuclear export mediator factor NEMF; Ribosome quality control complex subunit NEMF; Serologically defined colon cancer antigen 1; serologically defined colon cancer antigen 1 homolog; unnamed protein product
基因别名: 1500011I12Rik; 4933405E14Rik; IDDSAPN; NEMF; NY-CO-1; RQC2; SDCCAG1
UniProt ID: (Human) O60524, (Mouse) Q8CCP0
Entrez Gene ID: (Human) 9147, (Rat) 100322884, (Mouse) 66244